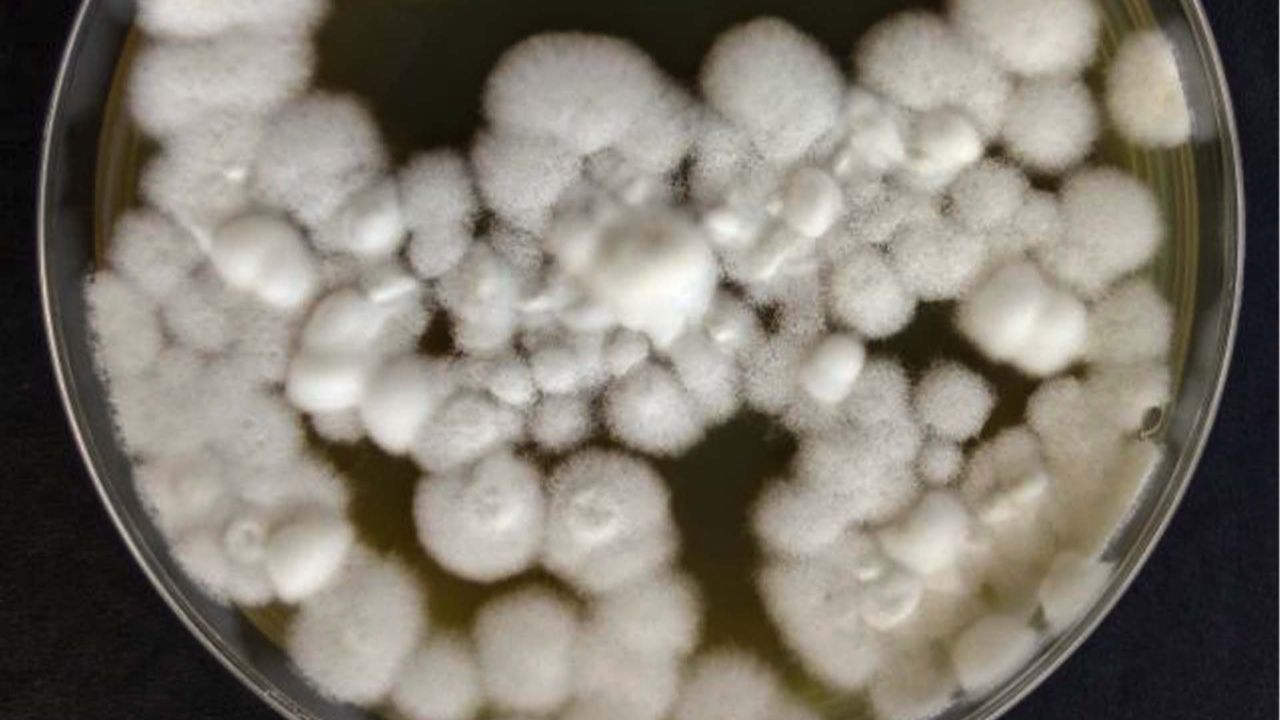
Cepa Beauveria bassiana

Pesquisa na Argentina revela que fungo nativo Beauveria bassiana elimina mais de 80% das formigas-argentinas em até cinco dias, oferecendo controle biológico sustentável e eficaz
Pesquisadores na Argentina deram um passo inédito no controle biológico das formigas-argentinas, uma das espécies invasoras mais destrutivas do planeta. A novidade vem de uma cepa de fungo nativo que oferece uma alternativa sustentável aos métodos químicos tradicionais.
A cepa Li053 do fungo entomopatogênico Beauveria bassiana foi testada em laboratório e causou mortalidade superior a 80% nas operárias da espécie Linepithema humile.
Em apenas dois a cinco dias após a exposição ao fungo, as formigas começaram a morrer, revelando o potencial do microrganismo como ferramenta de combate.
-
Por mais de 400 anos, marinheiros relataram cruzar um oceano que brilhava no escuro como neve, sem ondas e sem reflexos, apenas um brilho uniforme se estendendo até o horizonte, e em 2019 um satélite registrou o fenômeno cobrindo mais de 100.000 km² por mais de 40 noites seguidas ao sul de Java, mas os cientistas ainda não sabem exatamente o que desencadeia o processo
-
Japão vira referência com processo genial que recicla 100 toneladas de plástico por dia usando técnica que remove contaminantes, sensores ópticos que separam PP e PE em segundos e linhas industriais que transformam toneladas de resíduos em paletes reutilizáveis.
-
China criou máquina ‘impossível’ que muda a agricultura ao combinar drones, tratores autônomos com navegação centimétrica, sensores e inteligência artificial
-
A cidade flutuante movida a 2 reatores nucleares que abandona o vapor, usa campos eletromagnéticos para lançar aeronaves ao céu e inaugura uma nova era dos porta-aviões de guerra
O perigo das formigas-argentinas
As formigas-argentinas formam supercolônias que se estendem por vastas regiões, eliminando espécies nativas e desequilibrando ecossistemas.
Elas também se tornaram uma dor de cabeça para o setor agrícola e a apicultura: invadem colmeias, obrigam abelhas a abandonarem seus ninhos, protegem pragas como pulgões e ainda danificam mangueiras de irrigação ao perfurá-las.
O uso de inseticidas tem sido a principal estratégia de controle. Porém, trata-se de uma solução cara, ineficaz a longo prazo e prejudicial a organismos não-alvo, como polinizadores e predadores naturais.
Uma solução sustentável e eficaz
Em busca de alternativas menos agressivas ao ambiente, a equipe liderada pelas cientistas Patricia Folgarait e Daniela Goffré isolou seis cepas de fungos a partir de formigas mortas coletadas em reservas naturais da província de Buenos Aires.
Os testes laboratoriais envolveram três métodos de aplicação: tópica, pulverização e imersão. Cada um deles foi aplicado em operárias de quatro supercolônias diferentes.
A cepa Li053 de B. bassiana se destacou em todos os casos, causando alta mortalidade independentemente da origem das formigas ou do tipo de inoculação.
Resultados que impressionam
A infecção pelo fungo foi confirmada em até 92% dos cadáveres analisados. Além disso, concentrações maiores de esporos aumentaram a letalidade e aceleraram o tempo de morte.
A dose letal média (LC50) foi estimada em 1 x 10⁶ conídios/mL, um índice promissor para o desenvolvimento de bioinseticidas.
Outras cepas testadas também provocaram mortes, mas sem recuperação do fungo nos corpos, o que pode indicar causas externas ou limitações na colonização.
A Li053, no entanto, apresentou desempenho constante e confiável.
Potencial de aplicação no campo
O uso de um inimigo natural como o B. bassiana Li053 é promissor por ser uma solução específica, segura e sustentável.
Por ser uma espécie de fungo nativa da região, o risco de desequilíbrio ambiental é menor, favorecendo sua aplicação em larga escala.
Os próximos passos da pesquisa envolvem testes em campo, formulações comerciais e estudos ecológicos aprofundados para garantir a segurança ambiental do uso em áreas abertas.
O avanço representa uma nova etapa no enfrentamento das formigas-argentinas com tecnologias alinhadas ao manejo ecológico.
Clique aqui para ler a pesquisa.
Seja o primeiro a reagir!